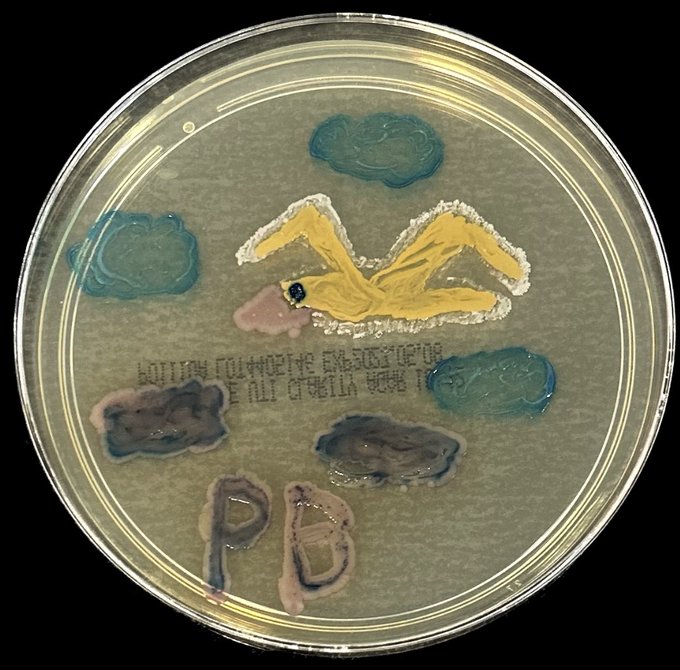
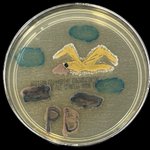
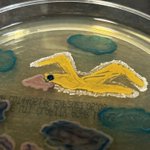
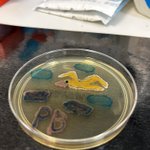

Queue cookie baker ~ Golden hour meme maker ~ Crown crew🫶🏻 ~ microbiology artist
- 514 following
- 824 followers
- Follow
This page is posted using the API in accordance with "Twitter Terms of Service". Learn more.
約2 件